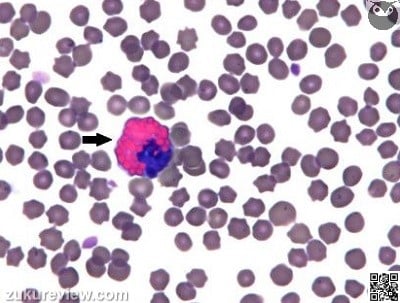
ee1sm 120

Wednesday, February 4
Question of the Day
What types of disease processes are typically associated with increases in the leukocyte indicated in this image of a blood smear?
(This image happens to be from a horse, but the mechanisms are similar across species).
